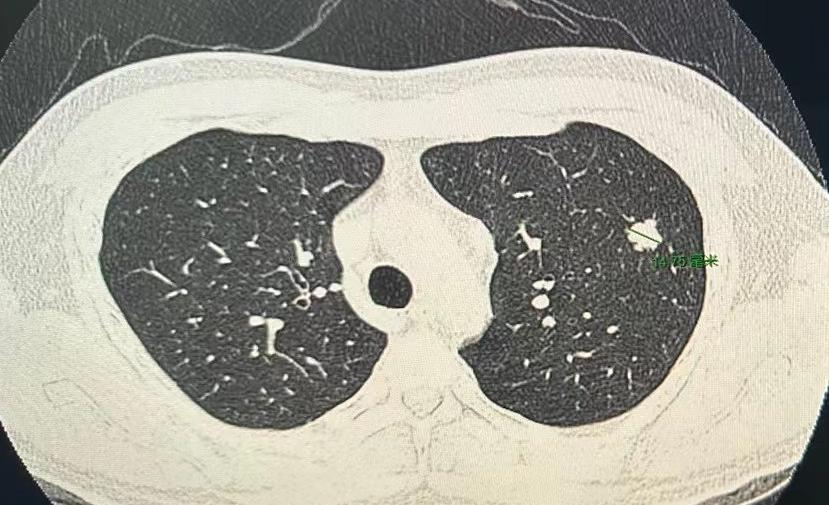
门诊看了五十多位患者，连着做了五台手术，有一台让我心情特别沉重！一位才33岁的小

我跟你讲个事儿,绝了。 一个阿姨,肚子疼了20天,跑去做CT,报告白纸黑字写着:胆囊没毛病。 可她就是疼啊!转头又去做了个B超,好家伙,B超上清清楚楚,一堆石头。 同一个胆囊,同一个时间,俩机器,两种命。 这找谁说理去? 后来才知道,石头这玩意儿,也分“三好学生”和“隐形刺客”。 阿姨得的那种,叫胆固醇结石。说白了,就是一肚子“油”结晶了。 这东西密度低,跟胆汁儿差不多。 在普通CT眼里,它俩就是一伙儿的,跟透明的冰块扔进了白开水里一样,根本看不出来。CT报告当然写“没事”。 但B超不一样,它靠的是耳朵,是声波。 石头和液体,在它听来,动静完全不同。一下就给揪出来了。 所以啊,有时候真不是机器骗你。 是你身体里那个“对手”太狡猾。 这事儿给我最大的感触就是,别太迷信一张报告。 尤其是当你的身体还在持续发出警报的时候。 你的疼,你的难受,才是最真实的报告。 机器是死的,人是活的。多问一句,换个法子查,可能就是天壤之别。 千万,千万要信你自己的身体。 它不会骗你。

用户10xxx46
结石先看CT? 不理解